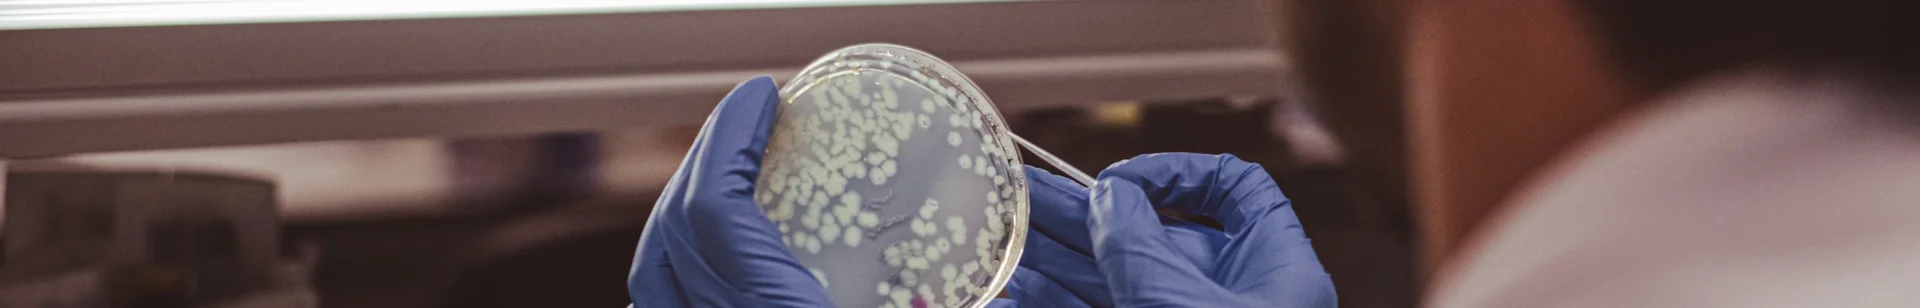

Serveis
Plataformes científico-tècniques
Les plataformes científicotècniques de l'IdISBa són un conjunt integrat de recursos, tant tècnics com humans i que faciliten l'accés a les tecnologies avançades, les infraestructures, el coneixement especialitzat i la capacitació necessària per impulsar el desenvolupament de la recerca traslacional.
La seva missió és donar suport científic i tecnològic als grups de recerca de l'IdISBa, així com a institucions externes, afavorint el desenvolupament de projectes de recerca i innovació en salut.
Actualment, l'IdISBa disposa d'aquestes plataformes:
- Biobanc
- Citometria i Biologia Cel·lular
- Cirurgia Experimental i Estabulari
- Unitat De Recerca Clínica I Assaigs Clínics (UBICEC)
- Genòmica i Bioinformàtica
- Microscòpia
- Proteòmica
- Investigació en Informació en Salut (PRISIB)
- Plataforma d’Imatge Molecular i Espectrometria de Masses (PT-IMEM)
- Serveis científico-tecnològics